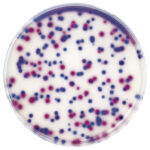

Un medio de cultivo microbiano es una mezcla de sustancias que promueve y apoya el crecimiento y diferenciación de microorganismos.
Los medios de cultivo contienen nutrientes, fuentes de energía, factores que promueven el crecimiento, minerales, metales, sales tampón y agentes gelificantes (para medios sólidos).
Las sofisticadas formulaciones de los medios de cultivo MERCK aseguran resultados de pruebas microbiológicas precisas, reproducibles y repetibles.
Los medios de cultivo siguen siendo el estándar de oro en la industria farmacéutica y de alimentos y bebidas para enumerar y detectar microorganismos.
Los medios de cultivo microbianos se pueden preparar como líquidos (caldo), sólidos (placas de agar) o semisólidos.
Los medios sólidos y semisólidos contienen un agente solidificante como agar o gelatina.
El portafolio de MERCK incluye una amplia gama de medios de cultivo deshidratados, en polvo o gránulos.
La tecnología de granulación superior proporciona la máxima comodidad, seguridad y cumple con los más altos estándares de rendimiento de la industria.
Los medios listos para usar se producen en condiciones estandarizadas y resuelven numerosos problemas en los laboratorios de microbiología, donde el tiempo, el equipo y el personal capacitado suelen ser escasos.
También ofrecemos placas de agar listas para usar de 90 y 55 mm, botellas de medios líquidos, tubos o ampollas de 2 ml, caldos y líquidos de enjuague para su aplicación de análisis microbiano.
Ofrecemos distintas calidades de medios de cultivo según la necesidad.
- NutriSelect®: medios de cultivo en polvo
- GranuCult®: medios de cultivo granulados
- EcoCult®: medios de cultivo en polvo en envases de 5 Kg y 10 Kg para grandes consumos.
- Medios de cultivo calidad “PRIME”: cumplen las más altas exigencias normativas, ideal para los clientes más exigentes.
Control de calidad: test de promoción de crecimiento bajo los estándares de ISO, FDA-BAM, EP, USP y bajo acreditación ISO 17025 - Medios de cultivo calidad “PLUS”: cumplen con las exigencias normativas de la industria alimenticia y de bebidas
Control de calidad: test de promoción de crecimiento de acuerdo a estándares de la industria.
Aseguramiento de calidad de acuerdo a ISO 9001 - Medios de cultivo calidad “BASIC”: ideal para quienes buscan economizar
Control de calidad básico
Aseguramiento de calidad de acuerdo a ISO 9001
Ver folleto:
Chromocult®: Los sustratos cromógenos utilizados en los medios Chromocult® confieren colores claramente distinguibles a diferentes tipos de colonias, permitiendo una diferenciación e identificación claras de los microorganismos

Los medios cromógenos se basan en el principio de que una enzima característica del organismo de interés rompe un sustrato cromógeno en un componente de la familia de los azucares y un cromógeno. En presencia del oxígeno, el cromógeno forma un dímero que colorea el caldo o la colonia típica. Los sustratos cromógenos utilizados en los medios Chromocult® confieren colores claramente distinguibles a diferentes tipos de colonias, permitiendo una diferenciación e identificación clara de los microorganismos.
Fluorocult®: medios de cultivo fluorogénicos. Fluorecen bajo la luz UV, lo cual permite identificar y cuantificar en simultaneo. Merck ofrece una amplia gama de medios de cultivo sólidos y líquidos que también permiten, por ejemplo, la detección mediante fluorescencia de E. coli con el nombre comercial Fluorocult®. Los medios de cultivo Fluorocult® tienen los mismos componentes que los medios convencionales y además el sustrato MUG, fluorescente. Algunos de los medios también contienen triptófano como sustrato para una posible reacción indol para confirmar adicionalmente la presencia de E. coli. Este método puede producir un resultado positivo en solo 24 horas.
Detección de coliformes en la industria alimentaria con medios fluorógenos.
Los medios Fluorocult® se introdujeron en 1986 para acortar el tiempo transcurrido hasta el resultado y reducir el costo por prueba. El principio en que se basan estos medios Fluorocult® consiste en que una enzima, característica del organismo de interés, rompe un sustrato fluorógeno en un componente azúcar o aminoácido y en metilumbeliferona. La luz UV hace que la metilumbeliferona sea visible y esto se utiliza para analizar la placa resultante. La fluorescencia azul típica de la sustancia indica un resultado positivo. Para la detección de Escherichia coli o de E. coli O157, por ejemplo, se añade el sustrato MUG (4-metilumbeliferil-β-D-glucurónido) a los medios tradicionales y para la detección rápida de Clostridium perfringens se introduce el sustrato metilumbeliferilfosfato.

Los medios Fluorocult® se introdujeron en 1986 para acortar el tiempo transcurrido hasta el resultado y reducir el costo por prueba. El principio en que se basan estos medios Fluorocult® consiste en que una enzima, característica del organismo de interés, rompe un sustrato fluorógeno en un componente azúcar o aminoácido y en metilumbeliferona. La luz UV hace que la metilumbeliferona sea visible y esto se utiliza para analizar la placa resultante. La fluorescencia azul típica de la sustancia indica un resultado positivo. Para la detección de Escherichia coli o de E. coli O157, por ejemplo, se añade el sustrato MUG (4-metilumbeliferil-β-D-glucurónido) a los medios tradicionales y para la detección rápida de Clostridium perfringens se introduce el sustrato metilumbeliferilfosfato.
Readycult®:
Los medios Readycult® permiten el estudio de enterococos y coliformes o de E. coli. Contienen el reactivo indol de KOVAC para confirmar además la presencia de E. coli. Estos medios se suministran en un formato de sobres «snap-pak» listos para usar que permiten una preparación rápida y sencilla. Los resultados se obtienen a las 18 a 24 horas de la incubación. Cualquier viraje de color del caldo de cultivo a azul verdoso, aunque sólo sea en la parte superior, es un resultado positivo.
Readybag ®: Bolsas de medios granulados pre-pesados e irradiados con rayos gamma, por lo que lo único que tiene que hacer es agregar agua esterilizada antes de incubar. Diseñados para pruebas de patógenos alimentarios





